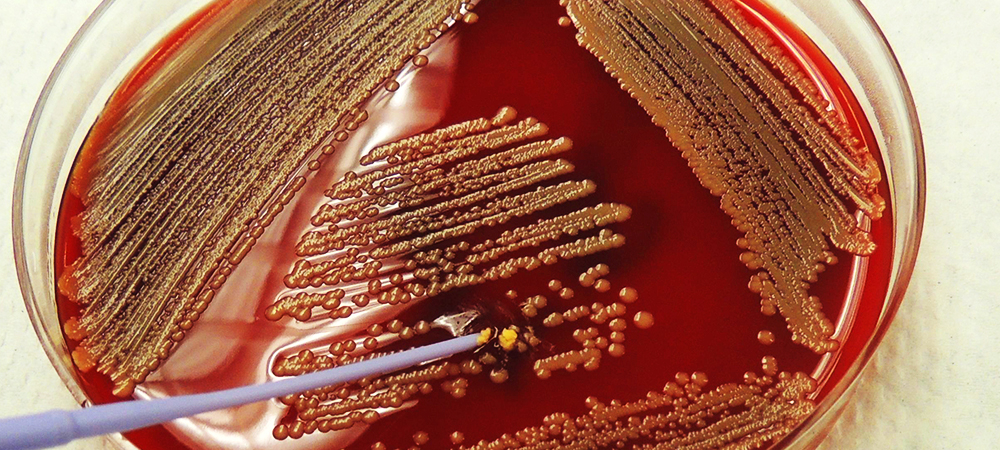
Mastitis

Research
Our favorite research topics are:
Johne's disease : susceptibility, transmission, immunology, vaccinology, pathogenomics, pathogenesis, diagnostics, molecular epidemiology
Bovine Mastitis : non-aureus staphylococci, antimicrobial resistance, bacterial genomics, mouse model
Digital Dermatitis : diagnostics, pathogenesis, mouse model, immunology
Biosensors and Molecular Diagnostic development : detection of protein biomarkers of infectious diseases, colostrum testing

Johne's Disease
Mycobacterium avium subsp. paratuberculosis is the causative organism of Johne′s disease (or paratuberculosis), a debilitating chronic gastroenteritis in ruminants. Animals typically become infected by the fecal-oral route in the first few months of life. The chronic wasting and profuse diarrhea that characterize clinical paratuberculosis are not usually observed until three or more years following infection. Paratuberculosis is prevalent in domestic animals worldwide and has a significant impact on the global economy, including the Canadian economy.
Check out our 2017 review paper on Johne's disease knowledge gaps

Digital Dermatitis
Digital dermatitis (DD), the leading cause of infectious lameness in Alberta dairy cattle, is present in 15% of cows and 94% of herds. The painful, ulcerative or proliferative lesions that characterize DD compromise animal welfare and lead to significant economic losses. Multiple species of Treponema, a pathogenic anaerobic bacterium, are consistently found in DD lesions and rarely isolated from healthy hooves. We developed qPCR assays for all major DD-associated bacteria and investigated their association with DD lesions. We are currently looking at the species present at the onset of DD lesions and in chronic lesions. Specifically, we are looking at Mycoplasma spp. in these chronic and recurring lesiosn.
Check out our 2017 review paper on missing pieces of the puzzle in DD control.
Mastitis
Non-aureus staphylococci (NAS), also called coagulase-negative staphylococci, have become the predominant pathogens causing intramammary infections (IMI) in dairy cattle in many countries. Moreover, NAS are the most frequently isolated pathogens from udder quarters; approximately 20% of milk samples collected on the farms enrolled in the Canadian Bovine Mastitis Research Network (CBMRN) was CNS-positive (Reyher et al., 2011). Little is known about the impact as well as control of NAS as compared to the common mastitis pathogens.
We have identified 6000 NAS/CNS isolates by rpoB sequencing, resolving the epidemiology in bovine mastitis in Canada. From this we selected >400 isolates for whole genome sequencing (WGS). These WGS have allowed us to study the phylogeny of these bovine NAS, their virulence gene and antimicrobial resistance gene profiles and their phenotypic and genotypic capacity to produce bacteriocins. And we discovered a new species, Staphylococci debuckii.
We are currently investigating the virulence genes and adaptation of S. chromogens for the mammary gland of dairy cattle.
Check out our review paper on non-aureus staphylococci in mastitis.

Biosensors and Molecular Diagnostics
Our lab develops novel diagnostic tests and devices for point-of-care and on-farm applications.
We are creating novel test platforms for detecting protein biomarkers, antibodies, small molecules and bacterial pathogens directly and instantly in biological samples that are the first of their kind.